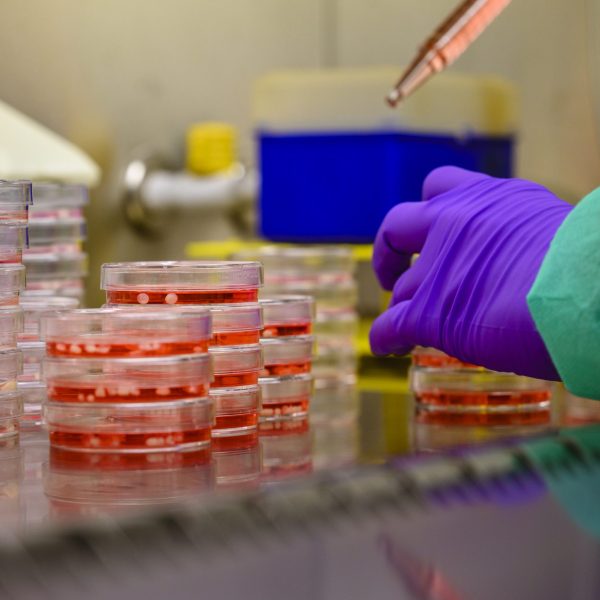

BRAINS stimuleert onderzoek naar hersenaandoeningoverstijgende problemen, zoals het doorlaten van medicijnen door de bloed-hersenbarrière, medische technologie, ambulante monitoring en humane hersenmodellen. Op dit moment wordt er door alle betrokken partijen actief gewerkt aan vijf projecten. In totaal wil BRAINS 15 miljoen euro investeren in onderzoek over tien jaar.
Onderzoekslijn 1: Bloed-hersenbarrière
In Nederland hebben ruim 4 miljoen mensen een hersenaandoening. Veel van deze aandoeningen zijn niet of nauwelijks te behandelen. Dat komt onder andere doordat de hersenen moeilijk bereikbaar zijn voor medicijnen en andere behandelingen.
Onze hersenen zijn namelijk goed beschermd door de schedel, die klappen van buitenaf opvangt. En door de bloed-hersenbarrière, die voorkomt dat schadelijke stoffen in de hersenen kunnen komen. Dit heeft één groot nadeel: het maakt het behandelen van hersenaandoeningen enorm moeilijk, want hierdoor kunnen ook sommige medicijnen de hersenen niet bereiken.
Deze onderzoekslijn valt binnen thema 1: Bloed-hersenbarrière.
Onderzoekslijn 2: Verbeterde MRI techniek voor hersenaandoeningen
BRAINS ondersteunt onderzoek naar betere MRI-technieken voor mensen met een hersenaandoening. MRI is een belangrijk en veilig onderzoek waarmee gekeken wordt wat er in de hersenen gebeurt. Met nieuwe slimme technieken, en in combinatie met kunstmatige intelligentie, kunnen artsen sneller en beter zien wat er mis is. Zo krijgen mensen sneller de juiste diagnose en behandeling.
Deze onderzoekslijn valt binnen thema 2: Hersenspecifieke technieken voor onderzoek en zorg
Onderzoekslijn 3: Menselijke celmodellen voor onderzoek naar gliose
Bij veel hersenaandoeningen raken hersencellen ontstoken, dit heet gliose. Wanneer gliose in de hersenen optreedt, verliezen cellen hun ondersteunende functie. Dat kan bijvoorbeeld leiden tot dementie, epilepsie of MS. BRAINS richt zich daarom ook op onderzoeksprojecten die zich volledig richten op gliose. Om dit te onderzoeken zijn menselijke celmodellen nodig. Daarmee kunnen onderzoekers beter begrijpen wat er precies misgaat in de hersenen van patiënten. Ook kunnen ze hiermee medicijnen testen die beter passen bij de patiënt. De kennis die hiermee wordt opgedaan is tegelijkertijd ook belangrijk voor andere hersenaandoeningen.
Deze onderzoekslijn valt binnen thema 2: Hersenspecifieke technieken voor onderzoek en zorg